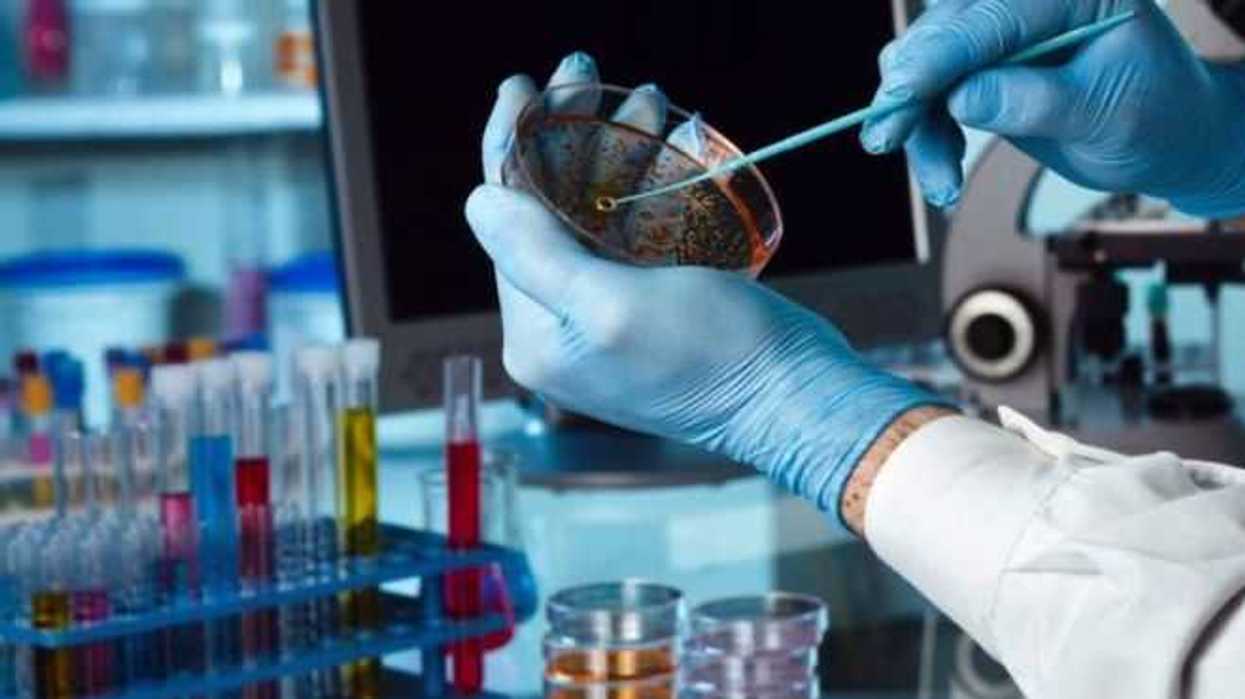
biotecnologia-union-de-ciencias-con-impacto-en-la-salud

México, 21 Mar (Notimex).- En el área de la salud, la multidisciplina contribuye al desarrollo de técnicas que han demostrado la efectividad en medidas de prevención, tratamiento o cura de padecimientos.
La biotecnología es una muestra de la unión de diferentes ciencias, y sus aportaciones a la medicina moderna se tratarán en el Biotech Summit, encuentro que reunirá a especialistas en biotecnología, cardiología y orteoporosis, del 23 al 24 de marzo en Cancún, Quintana Roo.
Jorge Morales Torres, especialista en reumatología del Hospital Aranda de la Parra en León, Guanajuato, y quien participará en el encuentro, señaló que los padecimientos del mundo moderno demandas la coordinación de esfuerzos. “El desarrollo de una máquina no resolverá los problemas, sino la unión de conocimientos”.
Agregó que en Biotech Summit los expertos evaluarán avances, pero también identificaran caminos para buscar respuestas a nuevos retos, principalmente en las áreas de cardiovascular y osteoporosis.
En entrevista con Notimex dijo que uno de los mejores ejemplos de la vinculación entre las ciencias básicas, la ingeniería y especialistas clínicos, es el electrocardiograma, gráfico que registra y describe los movimientos del corazón. Enumeró otras tecnologías que han sido importantes como los sistemas para medir presión, colesterol, así como el desarrollo de marcapasos.
Morales Torres agregó que al mismo tiempo en que el mundo científico une esfuerzos para contribuir a la atención de padecimientos, es necesario lograr una mayor “democratización” de los servicios de salud, así como combatir en la sociedad la falta de información y el auto medicamento.
Consideró que el médico familiar juega un papel importante en fomentar medidas preventivas. “Cuando el paciente acude con el médico de contacto porque tiene un cuadro gripal, éste puede realizar un chequeo más exhaustivo para identificar otros posibles padecimientos. Son intervenciones simples que pueden cambiar el futuro de individuos", enfatizó.
Agregó que los especialistas de la salud tienen la responsabilidad de actualizarse constantemente, para ofrecer una mejor atención.
Además de la participación del médico Morales Torres, Biotech Summit contará con la asistencia de los doctores Serge Ferrari y Patricia Clark, quienes hablaran de la osteoporosis; los doctores Xavier Escudero, Abel Pavía, Jorge Cortez y Roopa Mehta expondrán temas sobre problemas cardiovasculares; y los ponentes Gabriel Vargas, Jorge Morales, Bill Richard, Ricardo Correa, Carin Bonar y Mark Hamrick, explorarán los avances en biotecnología.
La biotecnología es una muestra de la unión de diferentes ciencias, y sus aportaciones a la medicina moderna se tratarán en el Biotech Summit, encuentro que reunirá a especialistas en biotecnología, cardiología y orteoporosis, del 23 al 24 de marzo en Cancún, Quintana Roo.
Jorge Morales Torres, especialista en reumatología del Hospital Aranda de la Parra en León, Guanajuato, y quien participará en el encuentro, señaló que los padecimientos del mundo moderno demandas la coordinación de esfuerzos. “El desarrollo de una máquina no resolverá los problemas, sino la unión de conocimientos”.
Agregó que en Biotech Summit los expertos evaluarán avances, pero también identificaran caminos para buscar respuestas a nuevos retos, principalmente en las áreas de cardiovascular y osteoporosis.
En entrevista con Notimex dijo que uno de los mejores ejemplos de la vinculación entre las ciencias básicas, la ingeniería y especialistas clínicos, es el electrocardiograma, gráfico que registra y describe los movimientos del corazón. Enumeró otras tecnologías que han sido importantes como los sistemas para medir presión, colesterol, así como el desarrollo de marcapasos.
“Los grandes avances médicos, no están en las máquinas, si no en la capacidad de analizar la información científica y tecnológica; la cardiología por ejemplo, es una de las áreas que ha sido beneficiada dramáticamente por la colaboración entre ingenieros, inmunólogos y cardiólogos”.Señaló que unir esfuerzos de la academia y lograr mayor vinculación entre los investigadores y la industria, es la única forma en que los avances científicos pueden traducirse en un beneficio que impacte al “hombre de la calle”.
Morales Torres agregó que al mismo tiempo en que el mundo científico une esfuerzos para contribuir a la atención de padecimientos, es necesario lograr una mayor “democratización” de los servicios de salud, así como combatir en la sociedad la falta de información y el auto medicamento.
Consideró que el médico familiar juega un papel importante en fomentar medidas preventivas. “Cuando el paciente acude con el médico de contacto porque tiene un cuadro gripal, éste puede realizar un chequeo más exhaustivo para identificar otros posibles padecimientos. Son intervenciones simples que pueden cambiar el futuro de individuos", enfatizó.
Agregó que los especialistas de la salud tienen la responsabilidad de actualizarse constantemente, para ofrecer una mejor atención.
Además de la participación del médico Morales Torres, Biotech Summit contará con la asistencia de los doctores Serge Ferrari y Patricia Clark, quienes hablaran de la osteoporosis; los doctores Xavier Escudero, Abel Pavía, Jorge Cortez y Roopa Mehta expondrán temas sobre problemas cardiovasculares; y los ponentes Gabriel Vargas, Jorge Morales, Bill Richard, Ricardo Correa, Carin Bonar y Mark Hamrick, explorarán los avances en biotecnología.

El equipamiento de seguridad certificado reduce hasta 50% las lesiones mortales en accidentes de motocicleta.Fuente: Unsplash
El equipamiento de seguridad certificado reduce hasta 50% las lesiones mortales en accidentes de motocicleta.Fuente: Unsplash








Meizu Lucky 08 5G: diseño simétrico y una pantalla impresionante.
Meizu Lucky 08 5G: diseño simétrico y una pantalla impresionante.
Meizu Lucky 08 5G: diseño simétrico y una pantalla impresionante.
